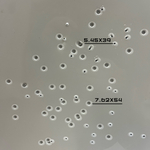
Мишень Силуэт-мини (пластиковая)

Мишень пластиковая Силуэт-мини от АЛЬФА Мобильный Полигон
Компактная пластиковая мишень Силуэт‑мини — решение для стрелковой подготовки и участия в соревнованиях различного уровня. Изделие выполнено из самозатягивающегося пластика толщиной 6 мм, что обеспечивает высокую износостойкость и позволяет минимизировать расходы на обновление мишенного оборудования.
Безопасность — один из ключевых приоритетов при разработке мишени. Благодаря особым свойствам материала, поглощающего энергию пули, полностью исключается риск рикошетов. Это делает мишень идеальным выбором для закрытых тиров, гарантируя защиту как стрелков, так и обслуживающего персонала.
Универсальность применения — ещё одно важное преимущество мишени ABCD. Она эффективно используется:
-
в стандартных стрелковых упражнениях;
-
на соревнованиях различного формата;
-
при отработке специальных тактических приёмов — в том числе на ультракоротких дистанциях при тренировке штурма окопа.
Таким образом, мишень подходит как для базовой огневой подготовки, так и для углублённых тактических занятий, позволяя отрабатывать широкий спектр стрелковых навыков в различных условиях.
Ключевое преимущество: технология самозатягивания
При попадании пули материал локально нагревается, плавится и «затягивает» пулевое отверстие. Мишень сохраняет целостность и функциональность даже после многократных попаданий. Ресурс — более 3 000 выстрелов патроном 7,62×54 мм ЛПС.
Основные характеристики:
-
материал: самозатягивающийся пластик;
-
толщина: 6 мм;
-
форма: уменьшенный силуэт (компактный формат для тренировок в ограниченном пространстве);
-
совместимость: комплекс тактико‑огневой подготовки БЛИК, подъёмная установка ТРОФЕЙ;
-
температурный режим: от −20 °C до +50 °C;
-
устойчивость: к влаге, механическим повреждениям, ультрафиолету.
Преимущества эксплуатации:
-
Безопасность. Полное отсутствие рикошетов — гарантия безопасности стрелков и персонала.
-
Долговечность. Выдерживает тысячи попаданий без потери функциональности.
-
Морозостойкость. Сохраняет пластичность при температурах до −20 °C.
-
Простота монтажа. Легко крепится на стандартные стойки и подъёмные механизмы.
-
Компактность. Удобна для тренировок в тирах с ограниченной площадью и на небольших полигонах.
-
Универсальность. Подходит для разных форматов тренировок и соревнований.
Области применения:
-
базовая огневая подготовка в учебных центрах и тирах;
-
тренировки в условиях ограниченного пространства;
-
отработка точности стрельбы на коротких дистанциях;
-
соревнования по практической стрельбе (в т. ч. в закрытых тирах);
-
занятия частных охранных предприятий;
-
начальная подготовка стрелков любого уровня.
Это практичное решение для тиров, учебных центров и полигонов, где важна экономия пространства. Мишень обеспечивает безопасные, эффективные и результативные тренировки при любых условиях эксплуатации.
Тактико-технические характеристики мишени из пластика Силуэт- мини
- Тип мишени: Мишени из пластика.
- Целевое назначение: Огневая подготовка, подготовка военнослужащих, IPSC, спортивная стрельба.
- Исполнение элементов: Самозатягивающийся пластик, толщина 6 мм).
- Цвет мишени: Серый.
- Габариты поражаемой зоны (ДхШ): 500х500 мм.
- Габариты мишени (ДхШхВ): 500х460х6 мм.
- Масса изделия: 0,8 кг.
- Описание работы: Пластиковая мишень — самозатягивающийся пластик (6 мм), выдерживает более 3000 выстрелов. Подходит для тренировок и соревнований, безопасна, морозостойка.
- Рекомендованная дистанция стрельбы:
- Пистолеты и револьверы — от 7 метров.
- Гладкоствольные ружья (пуля) — от 10 метров, (картечь) — от 10 метров.
- Автоматы и карабины (5.45х39, .223 Rem, 7.62х39) — от 10 метров.
- Винтовки (.308Win, 7.62х54R, 30-06Spr., 8х57) — от 50 метров.
- Рекомендации по боеприпасам: не рекомендуется использовать бронебойные или бронебойно‑зажигательные боеприпасы в связи с высокой вероятностью рикошета и повышенным износом мишени. Также не рекомендуется применять боеприпасы крупного калибра (например, 12,7 мм): после прохождения таких пуль через тело мишени пластик не успевает «затянуться», что приводит к необратимому повреждению мишени и сокращению её ресурса.
- Условия эксплуатации: -50 до +50°C.
- Гарантия: 12 месяцев (гарантия не распространяется на узлы подверженные естественному износу, либо части поврежденные в процессе неправильной эксплуатации).
- Доставка: По РФ 3-5 рабочих дней.

Оставьте свои контактные данные мы вышлем подробную информацию для вас